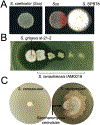

Ecological drivers of division of labour in Streptomyces
- PMID: 35468363
- PMCID: PMC12042799
- DOI: 10.1016/j.mib.2022.102148
Ecological drivers of division of labour in Streptomyces
Abstract
Division of labour occurs when different individuals, cells or tissues become specialised to perform complementary tasks that benefit the whole organism or social group. Although long studied in multicellular organisms and colonies of social insects, several recent studies have established that division of labour is common in microorganisms. We review recent work on the division of labour in unicellular and multicellular bacteria, with a particular focus on reproductive and metabolic divisions of labour in actinomycetes. Actinomycetes show enormous variation in sporophore morphology and spore production patterns that likely affect the potential for cooperative interactions within colonies. They also display both irreversible genetic and spatiotemporally regulated phenotypic divisions of labour that structure antibiotic production. We highlight outstanding questions in this group of multicellular bacteria and outline factors that can modify the expression of division of labour across microbes.
Copyright © 2022 The Authors. Published by Elsevier Ltd.. All rights reserved.
Figures

References
-
- Cooper GA, West SA. Division of labour and the evolution of extreme specialization. Nat Ecol Evol [Internet]. 2018. Jul 1 [cited 2021 Dec 10];2(7):1161–7. Available from: https://www.nature.com/articles/s41559-018-0564-9 - PubMed
-
- Fisher RM, Cornwallis CK, West SA. Group formation, relatedness, and the evolution of multicellularity. Curr Biol [Internet]. 2013. Jun 17 [cited 2016 Nov 14];23(12):1120–5. Available from: http://www.ncbi.nlm.nih.gov/pubmed/23746639 - PubMed
-
- Duarte A, Weissing FJ, Pen I, Keller L. An Evolutionary Perspective on Self-Organized Division of Labor in Social Insects. Annu Rev Ecol Evol Syst [Internet]. 2011. Dec 1 [cited 2021 Dec 10];42(1):91–110. Available from: https://www.annualreviews.org/doi/10.1146/annurev-ecolsys-102710-145017 - DOI
-
- Giri S, Waschina S, Kaleta C, Kost C. Defining Division of Labour in Microbial Communities. J Mol Biol [Internet]. 2019. Jun 28 [cited 2019 Jul 10]; Available from: https://www.sciencedirect.com/science/article/pii/S0022283619304127 - PubMed
-
This excellent review establishes testable criteria for studying microbial division of labour within and between species.
-
- Zhang Z, Claessen D, Rozen DE. Understanding Microbial Divisions of Labor. Front Microbiol [Internet]. 2016. Dec 21 [cited 2019 Jul 10];7:2070. Available from: http://journal.frontiersin.org/article/10.3389/fmicb.2016.02070/full - DOI - PMC - PubMed
Publication types
MeSH terms
Grants and funding
LinkOut - more resources
Full Text Sources